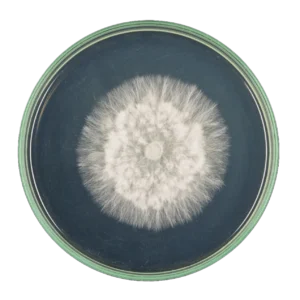
Placa Petri Setas

La información proporcionada en este sitio web tiene fines informativos y educativos. No pretende ser un sustituto del consejo médico profesional, diagnóstico o tratamiento, tratar, prevenir o curar ninguna enfermedad o condición Siempre consulta a tu médico u otro proveedor de salud calificado con cualquier pregunta que puedas tener sobre una condición médica.